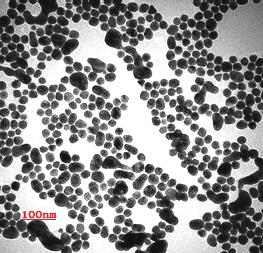

| 型號: | YQ-A01 |
|---|---|
| 品牌: | 源沁 |
| 原產地: | 中國 |
| 類別: | 化工 / 無機原料 / 其它無機原料 |
| 標籤︰ | 密度較低 |
| 單價: |
¥1000
/ 千克
|
| 最少訂量: | 1 千克 |
產品描述
納米氮化鋁微粉
TEL: 0572-5135 070 ,132 5092 5175
型號:YQ-A01
CAS:24304-00-5
YQ-A01納米氮化鋁,採用直接氮化法工藝生產,產品在抗彎強度和熱導率上明顯高于同類產品。用在高分子樹脂中,增黏不明顯,是目前最好的高導熱絕緣填料。
YQ-A01納米氮化鋁主要具有以下特性:
1.高純度 (99-99.99%,可定製)、粒徑分布範圍小(30-100nm,可定製)
2. 具有良好的導熱性,熱膨脹係數小、且可耐1400度高溫,可以大幅度提高塑料和硅橡膠的導熱率,是良好的耐熱衝擊材料。
3. 抗熔融金屬侵蝕的能力強,是熔鑄純鐵、鋁或鋁合金理想的坩堝材料
4. 具有優良的電絕緣性,介電性能良好,具有良好的注射成形性能;用於復合材料,與半導體硅匹配性好,界面相容性好,可提高復合材料的機械性能和導熱介電性能等。
主要技術指標:
|
平均粒徑D50(nm) |
50 |
|
比表面積(m2/g) |
≥58 |
|
純度(%) |
≥99.9 |
|
N(wt%) |
33.5 |
|
O(wt%) |
<0.05 |
|
Fe(ppm) |
<30 |
|
Ca(ppm) |
<30 |
其他純度、粒度規格可根據用戶要求提供定製服務
應用領域:
1.用作大功率半導體器件的絕緣基片、大規模和超大規模集成電路的散熱基片、鋰電池內部的隔板材料、切削工具、封裝材料、高溫潤滑劑、熱散板及粘結劑等。
2.製造集成電路基板、電子器件、光學器件、散熱器、高溫坩鍋;
3.制備金屬基及高分子基復合材料,特別是在高溫密封膠粘劑和電子封裝材料中有極好的應用前景。
4.導熱填料:如金屬、陶瓷及石墨基復合材料,橡膠、塑膠、塗料、膠粘劑及其它高分子基復合材料。
技術支持:
我司可提供YQ-A01納米氮化鋁在高性能陶瓷、工程塑料、特種塗料等領域的應用技術支持,具體應用咨詢請與銷售工程師聯繫。
包裝儲存:
1.應密封保存於乾燥、陰涼的環境中,不宜長久暴露于空氣中,防受潮發生團聚,影響分散性能和使用效果。
2.本產品體密度較低,容易漂浮在空氣中,取用時請勿造成較大的空氣擾動,以免吸入體內。
湖州源沁新材料有限公司
網址:http://www.hzyuanqin.com
電話:0572-5135070 ,13250925175
地址:浙江省湖州市云鴻西路1號
會員信息
| 湖州源沁新材料有限公司 | |
|---|---|
| 國家/地區︰ | 浙江省湖州市 |
| 經營性質︰ | 生產商 |
| 聯繫電話︰ | 13250925175 |
| 聯繫人︰ | 陳甦林 (經理) |
| 最後上線︰ | 2024/11/06 |